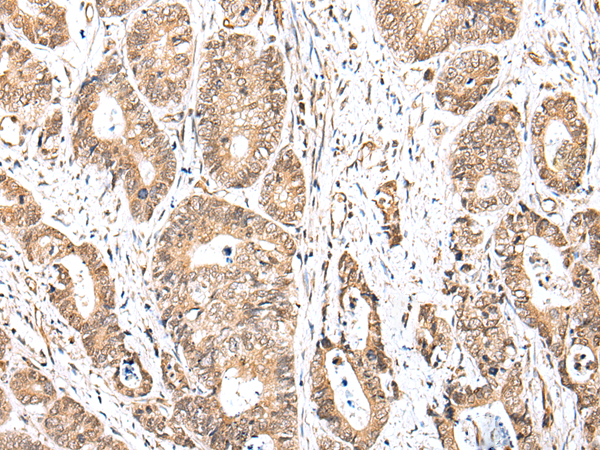

中文名稱:兔抗UBXN2B多克隆抗體
|
Background: |
UBXD2B (UBX domain-containing protein 2B), also known as NSFL1 cofactor p37 and p97 cofactor p37, is a 331 amino acid protein that contains one UBX domain and one SEP domain. UBXN2B is required for ER and Golgi biogenesis and also plays a role in their maintenance during interphase, as well as their reassembly at the end of mitosis. Through interaction with VCP, UBXN2B forms a complex that has membrane fusion activity. Adapter protein required for Golgi and endoplasmic reticulum biogenesis. Involved in Golgi and endoplasmic reticulum maintenance during interphase and in their reassembly at the end of mitosis. The complex formed with VCP has membrane fusion activity; membrane fusion activity requires USO1-GOLGA2 tethering and BET1L. VCPIP1 is also required, but not its deubiquitinating activity. |
|
Applications: |
ELISA, IHC |
|
Name of antibody: |
UBXN2B |
|
Immunogen: |
Fusion protein of human UBXN2B |
|
Full name: |
UBX domain protein 2B |
|
Synonyms: |
p37 |
|
SwissProt: |
Q14CS0 |
|
ELISA Recommended dilution: |
5000-10000 |
|
IHC positive control: |
Human gastric cancer |
|
IHC Recommend dilution: |
25-100 |
購(gòu)物車
購(gòu)物車 幫助
幫助
 021-54845833/15800441009
021-54845833/15800441009
